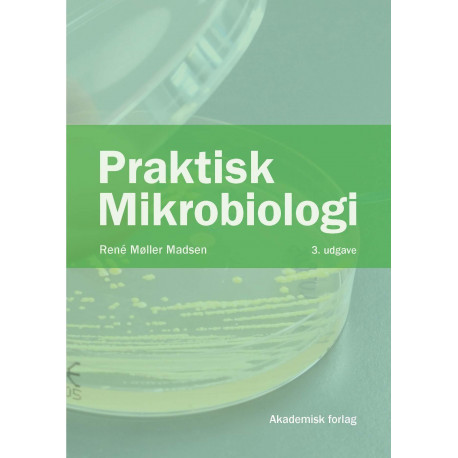

Ingen varer
Praktisk mikrobiologi
(Bog, Hæftet, Dansk)
- Type: Bog
- Format: Hæftet
-
Sprog:
Dansk

- ISBN-13: 9788750061328
- Se flere detaljer ▼
Bemærk: Kan leveres før jul.
Beskrivelse
Praktisk Mikrobiologi er en lærebog til undervisning af laboranter, procesteknologer og professionsbachelorer i ernæring og sundhed, men også andre kan få udbytte af at læse den.
Praktisk Mikrobiologi omhandler arbejdet i det mikrobiologiske laboratorium og hænger således sammen med Mikrobiologi ? Systematik ? Vækst ? Fødevarer, der tager sig af den teoretiske mikrobiologi.
Blandt bogens emner kan nævnes:
? Sikkerhed
? Præparater og mikroskopi
? Dyrkning af bakterier, morfologisk beskrivelse og undersøgelsesmetoder
? Substrater
? Rendyrkning og identifikation
? Svampeundersøgelse
? Kimtælling
? Desinfektion, sterilisation og hygiejnekontrol.
Praktisk Mikrobiologi er skrevet i et letlæseligt sprog - uden at gå på kompromis med fagligheden.
3. udgave af bogen er blevet fagligt opdateret og uddybet samt forsynet med nye illustrationer.
Måske kunne nedenstående have interesse
Se vores store udvalg af notesbøger i høj kvalitet. Vi har bl.a. notesbøger fra mærker som Moleskine og Paperblanks.
Læsernes anmeldelser (0)
Alle detaljer
| Forlag | Akademisk Forlag |
| Forfatter | René Møller Madsen |
| Type | Bog |
| Format | Hæftet |
| Sprog | Dansk |
| Udgave | 3. (20-06-2022) |
| Oplag | 1. (20-06-2022) |
| Første udgivelsesår | 2022 |
| Originalsprog | Dansk |
| Sideantal | 192 |
| Indbinding | Hæftet |
| Mål og vægt | B: 170mm, H: 12mm, D: 240mm, Vægt: 440g |
| ISBN-13 / EAN-13 | 9788750061328 |

